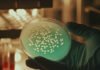
Arrestan en Utah al sospechoso de un asesinato ocurrido hace 20 años, gracias a pruebas de ADN

Elefantes “hambrientos” pisotearon a tres personas hasta la muerte mientras buscaban comida en la India.

Los elefantes entraron en una aldea, en el distrito de Goalpara del estado de Assam, cerca del bosque de Lakhipur, cuando ocurrió el incidente, informó The Times of India.
Las víctimas, identificadas como Sarati Lama, su hijo de 4 años, Sasit Biswakarma, y otro aldeano, Bhim Kumar Rai, se encontraron con la manada a las 3 de la madrugada, informó el medio de comunicación.
Aunque generalmente se les ve como gigantes gentiles, los elefantes pueden representar un peligro para los humanos cuando se sienten amenazados o provocados. El conflicto entre humanos y vida silvestre ha ido en aumento en las zonas rurales de la India debido a la falta de recursos.
Los animales a menudo deambulan por áreas pobladas en busca de comida, cuando escasea en su propio hábitat.
Según el medio mencionado, 12 de las 16 personas que murieron en ataques de elefantes en el distrito de Goalpara este año murieron en el área forestal de Lakhipur.
Dhruba Dutta, un oficial forestal de la cordillera forestal de Lakhipur, le dijo al medio local que después de ver a la manada cerca, los aldeanos opusieron resistencia.
“Las tres personas, muertas en el lugar, fueron perseguidas por la manada”, dijo Dutta.
Un oficial de policía le dijo al Indo-Asian News Service que lo más probable es que los elefantes estuvieran buscando comida cuando ocurrió el ataque, informó Newsroom Odisha.
Recientemente se han producido otros incidentes similares en toda la India.
En junio, un elefante mató a una mujer de 70 años en el distrito de Mayurbhanj de Odisha, en el este de India. Después de que la mujer murió, el elefante regresó a su funeral y pisoteó su cadáver, dijo la policía local en ese momento.
El conflicto entre humanos y elefantes también está aumentando debido a la pérdida de hábitats. A medida que crecen las áreas pobladas, los elefantes se ven obligados a acercarse más a los humanos.
El cambio climático también está aumentando las temperaturas en la India, provocando que las fuentes de agua se sequen. Esto está creando presión para la especie y obligándola a buscar recursos en otros lugares.
Te recomendamos: ¿Quiénes son los humanos más aptos para soportar un viaje a Marte?
La fragmentación de los hábitats también puede causar casos de “ataque de cultivos”, cuando los elefantes se pierden en las tierras de cultivo. Esto a menudo puede llevar a los granjeros a tomar represalias, creando peligro tanto para ellos como para los elefantes.
EL DIARIO NY
Esta y otras noticias en nuestro canal de Telegram TFPOficial; siguenos tambien por Instagram thefreedompost_